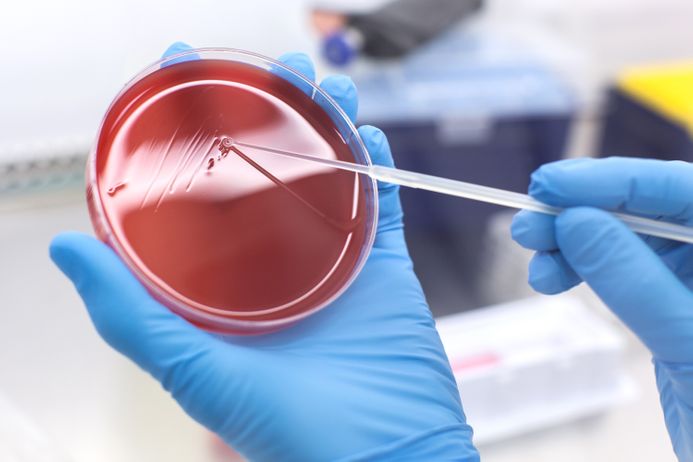

Top boxes
Your guide to industry collaboration and commercialisation
Site directory
Creating a spinout company
- What is a spinout company?
- Imperial's vision for spinout companies
- How to start a spinout
- Founder's Choice
- Expert business coaching and mentoring
- Imperial White City Incubator
- Finding funding for your spinout
- How we help you find investment
- Imperial College Enterprise Funds
- Knowledge Transfer Partnerships
- Finding a space for your startup